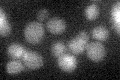
YMR292W
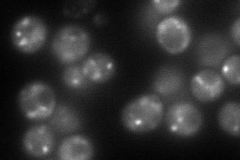
YMR292W
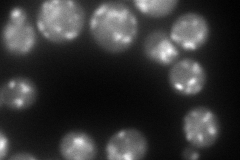
YMR292W
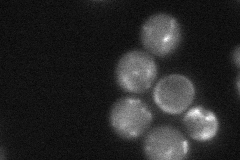
YMR292W
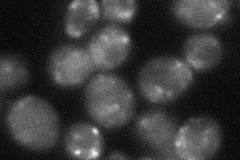
YMR292W
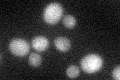
YMR292W
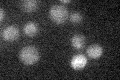
YMR292W

View description
Evolutionarily conserved non-essential protein present in early Golgi cisternae that may be involved in ER-Golgi transport at a step after vesicle tethering to Golgi membranes, exhibits membrane topology similar to that of Sft2p
Localization:
Intensity:
Fold change:
Significance:
-
C’ GFP library in SD
below threshold14.08 -
N' NOP1pr-GFP in SD
punctate113.292 -
N' TEF2pr-mCherry in SD
punctate208.007 -
N' NATIVEpr-GFP in SD
punctate40.7662 -
N' TEF2pr-VC and Cyto-VN in SD
punctate39.2185 -
C’ GFP library in SD+DTT
cytosol15.751.11No -
C’ GFP library in SD+H2O2

cytosol14.11No -
C’ GFP library in Starvation Media
cytosol17.241.22No -
C’ GFP library on the background of Pup2-DaMP

below threshold -
C’ GFP library on the background of CCT mutant

below threshold13.87870.985497No
